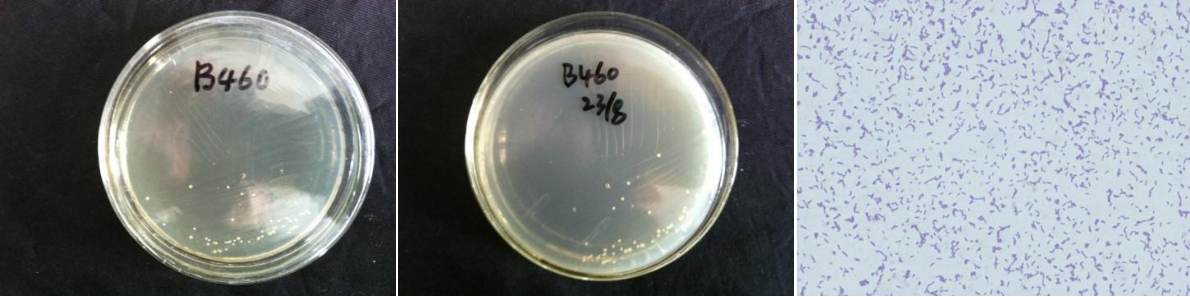

Loading...
| StrainNO | B460 |
| Classification | Cellulomonas |
| 16s rDNA sequence | CGCCGGTCCACCTTCGACGGCTCCCCTCTTGCGAGTTGGGCCACCGGCTTCGGGTGTTACCGACTTTCGTGACTTGACGGGCGGT GTGTACAAGGCCCGGGAACGTATTCACCGCAGCGTTGCTGATCTGCGATTACTAGCGACTCCGACTTCATGGGGTCGAGTTGCAG ACCCCAATCCGAACTGAGACCGGCTTTTTGGGATTCGCTCCACCTCGCGGTATCGCAGCCCTTTGTACCGGCCATTGTAGCATGC GTGAAGCCCAAGACATAAGGGGCATGATGATTTGACGTCATCCCCACCTTCCTCCGAGTTGACCCCGGCAGTCTCCTATGAGTCC CCACCATCACGTGCTGGCAACATAGGACGAGGGTTGCGCTCGTTGCGGGACTTAACCCAACATCTCACGACACGAGCTGACGACA ACCATGCACCACCTGTACACCGACCTTGCGGGGCAACCATCTCTGGAAGTTTCCGGTGTATGTCAAGCCTTGGTAAGGTTCTTCG CGTTGCATCGAATTAATCCGCATGCTCCGCCGCTTGTGCGGGCCCCCGTCAATTTCTTTGAGTTTTAGCCTTGCGGCCGTACTCC CCAGGCGGGGCACTTAATGCGTTTGCTGCGGCACGGAACTCGTGGAATGAGCCCCACACCTAGTGCCCAACGTTTACGGCATGGA CTACCAGGGTATCTAATCCTGTTCGCTCCCCATGCTTTCGCTCCTCAGCGTCAGTTGCGGCCCAGAGACCTGCCTTCGCCATCGG TGTTCCTCCTGATATCTGCGCATTCCACCGCTACACCAGGAATTCCAGTCTCCCCTACCGCACTCTAGTCTGCCCGTACCCACTG CAAGCCCGAGGTTGAGCCTCGAGTTTTCACAGCAGACGCGACAAACCGCCTACGAGCTCTTTACGCCCAATAATTCCGGACAACG CTTGCGCCCTACGTATTACCGCGGCTGCTGGCACGTAGTTAGCCGGCGCTTCTTCTGCAGGTACCGTCACTTGCGCTTCTTCCCT GCTGAAAGAGGTTTACAACCCGAAGGCCTTCATCCCTCACGCGGCGTCGCTGCATCAGGCTTGCGCCCATTGTGCAATATTCCCC ACTGCTGCCTCCCGTAGGAGTCTGGGCCGTGTCTCAGTCCCAGTGTGGCCGGTCGCCCTCTCAGGCCGGCTACCCGTCGTCGCCT TGGTAGGCCATCACCCCACCAACAAGCTGATAGGCCGCGAGCCCATCCCTGACCGATAAATCTTTCCAGACGCATCAGATGCCTG AACGTCACATATCCGGTATTAGACCTCGTTTCCAAGGCTTATCCCAGAGTCAGGGGCAGGTTACTCACGTGTTACTCACCCGTTC GCCACTGATCCACCCAGCAAGCTGGGCTCCACCGTGCGACTTGCATGGTAAGCACGCCCCCCC |
| Strain Morphology Photos | |
| Morphological Description | The morphology of Colony round;milky white;bun shape;edge neatly;light;sticky;The morphology of strain:Rod;no spores |